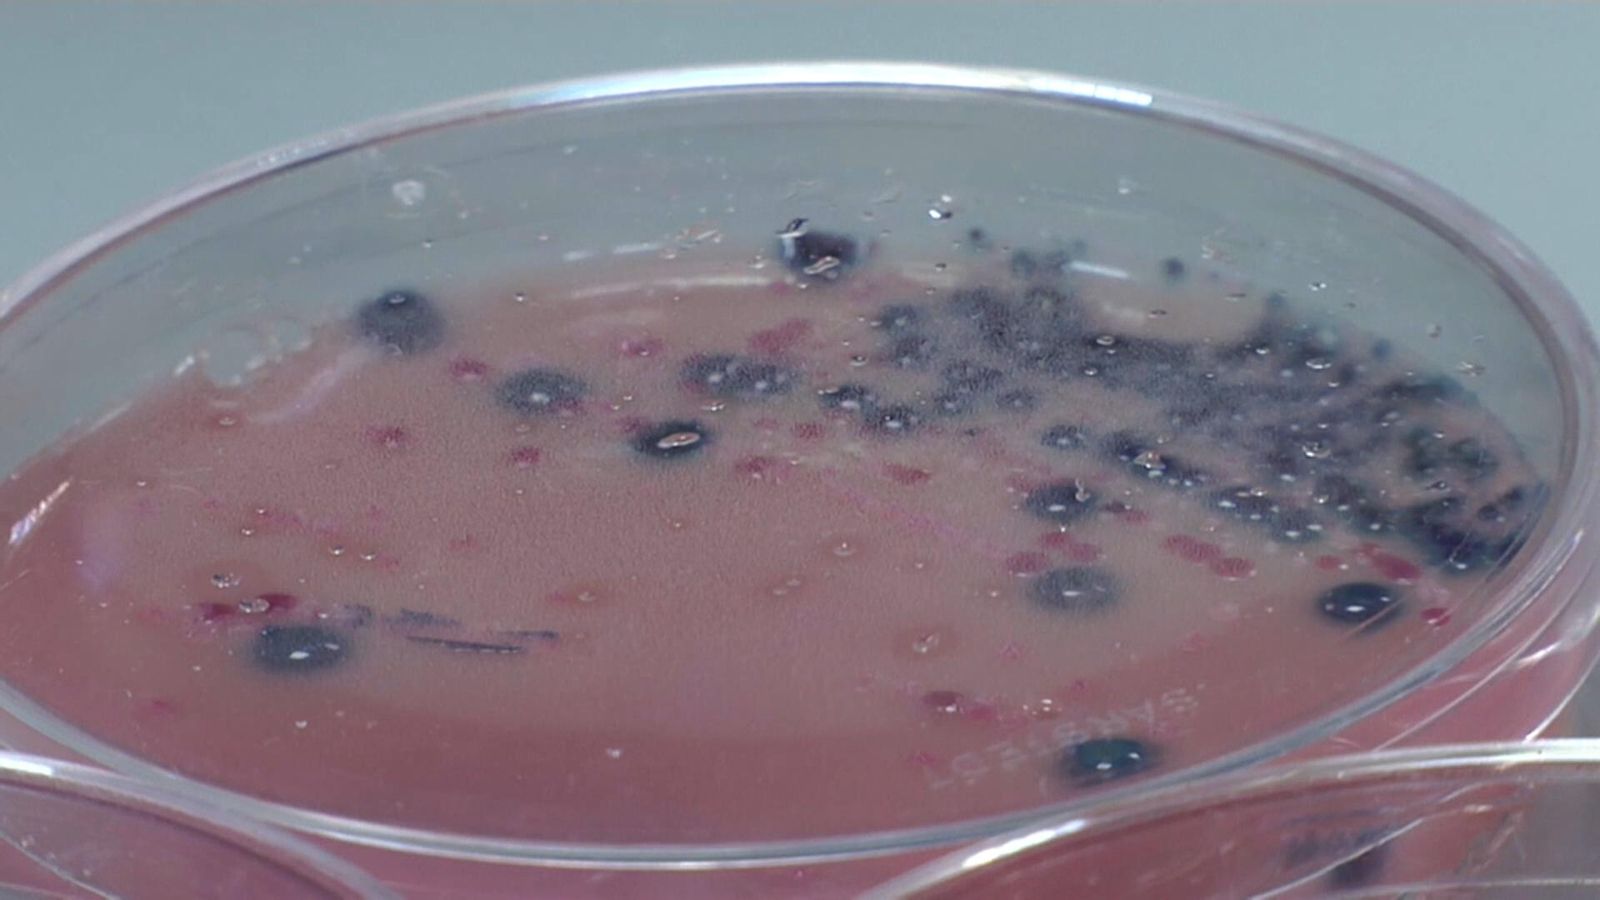

La concentració de Covid en les aigües residuals de València puja un 33% i suma quatre setmanes a l'alça
La setmana passada, la concentració de Covid es va disparar un 520% a la ciutat, que pateix una incidència acumulada de 511 casos
La concentració de Covid en les aigües residuals de la ciutat de València ha pujat un 33% en l'última setmana i acumula quatre setmanes seguides a l'alça, segons ha informat la regidora del Cicle Integral de l'Aigua, Elisa Valía.
L'increment és menor que la setmana passada, quan aquestes restes van créixer un 520%. Tanmateix, s'han superat els cent milions d'unitats genòmiques per litre de concentració de coronavirus, quan fa a penes un mes -el 8 de juny- les xifres no superaven els 4,5 milions.
L'edil ha dit que aquest alentiment de l'increment respecte a l'anterior setmana "era d'esperar", perquè l'augment de la setmana passada havia sigut molt gran, però ha realitzat una crida a la població perquè "respecte les normes" contra la Covid, ja que l'atenció primària "està començant a patir".
Les dades de l'últim mes reflecteixen l'increment de restes de coronavirus en aigües residuals: la setmana del 8 de juny es van registrar 4,5 milions d'unitats genòmiques per litre de concentració de coronavirus; la setmana del 15 de juny, aquesta xifra es va elevar a 7,5 milions; la setmana del 22 de juny, es va duplicar la quantitat fins als 13,8 milions; i la setmana del 29 de juny es va quintuplicar, arribant als a 72,4 milions. Ara es troba lleugerament per damunt dels cent milions, un 33% més.
La ciutat de València, en risc extrem amb la incidència en 511 casos
L'augment de la concentració de Covid en aigües residuals és una mostra més de l'empitjorament de la situació epidemiològica a la ciutat de València, que presenta una incidència a catorze dies de 511 casos per cada cent mil habitants, la més alta de tots els grans nuclis urbans valencians.
Les últimes dades facilitades per la Conselleria de Sanitat Universal informen de vora 5.000 nous contagis en les últimes dues setmanes només a la ciutat, amb comportament també a l'alça en l'àrea metropolitana.
